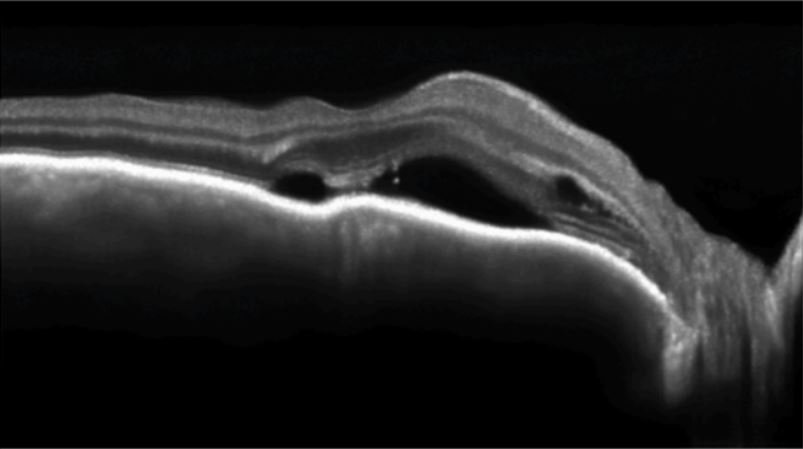
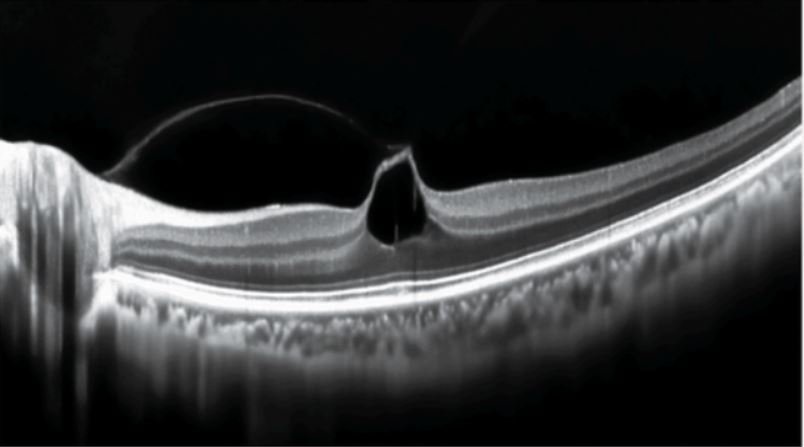

EOCT2 Ultimate OCT Angiography
High-Speed & Ultra-High Resolution Ultimate OCT Angiography Serving the Entire Process of Eye Health
Ultra-high resolution, wide-angle imaging Clear visualization of ocular fundus vessels
Fundus exploration at a glance

Acquisition image resolution up to 8K

High Speed 86, 000 A scan per second

Intelligence AI-assisted analysis empowers diagnosis
High definition vascular microcirculation imaging Function integration



- Visualization of 3D fundus imaging
- Rich details between layers
- High-resolution fundus imaging

Anterior segment detection - Accurate measurement

Panoramic anterior segment analysis | Panoramic anterior segment presentation • Corneal thickness map presentation Corneal dividing line Thickness measurement presentation
Glaucoma & macula detection - Automatic analysis

Glaucoma optic disc analysis | Optic disc data analysis • Thickness of RNFL • Thickness time zone • Quadrant chart



Al recognition for eye diseases · Precise localization of eye diseases

Automatic identification and annotation of fundus anomalies & Precise localization using Al big data model

Automatic generation of Al diagnostic analysis reports • and accuracy acy of of ophthalmic screening Improvement in the efficiency

Future health risk prediction • Comprehensive health assessment • Multi-dimensional information reference
Case maps exhibition